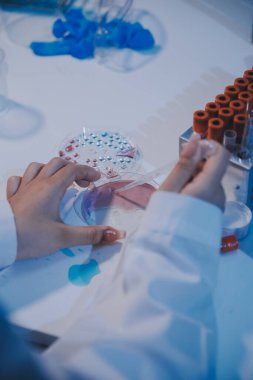
Araştırma, deney ve tıbbi deney laboratuvarda, bilim tesisinde ya da hastanede bir bilim adamı tarafından yapılıyor. Bir genç, ciddi ve profesyonel araştırmacı bir keşif yapıyor, düzenliyor ya da düzenliyor.

Araştırma, deney ve tıbbi deney laboratuvarda, bilim tesisinde ya da hastanede bir bilim adamı tarafından yapılıyor. Bir genç, ciddi ve profesyonel araştırmacı bir keşif yapıyor, düzenliyor ya da düzenliyor.
İhlal Bildirim Formu
Özel Boyut
(3648 x 5472, jpg)
Geniş Lisanslama
(3648 x 5472, jpg)
* Kurumsal aylık abonelikte çok avantajlı fiyatlar için tıklayın.
* Fiyatlara Kdv dahil değildir.
Örnek Kullanımlar: Web siteleri; reklam afişleri; ekran koruyucuları; sunumlar (PowerPoint, Flash, vs); filmler, videolar veya televizyon reklamları, gazete ve dergilerdeki reklamlar, bastırılmış reklam materyalleri; kitaplar için kapak, iş kartları; el ilanları; posterler; CD/DVD kapakları, etiketler veya ürün paketleri, kırtasiye, dosya, defterler, tükenmez kalem, kalemler, yapıştırmalar; takvimler; fincanlar veya bardaklar; fare altlığı; tişörtler, kıyafet vs. Detaylı Tablo için Tıklayınız!
En Çok Aranan Kelimeler
Yakın planfotoğrafçılıkdonanımSıvıİlaçteknolojiDoktorHastaneçalışmaGeliştirmemesleğiincelenmesiUzmanEğitimKonsantrasyonseyirKapalımalzemebiyolojiKimyasalKimyagerLaboratuvarBilimKeşiföğrencianalizkimyaYenilikaraştırmaTeknisyenBeherbiyokimyaBiyoteknolojibilim adamıMikroskopDNAMikrobiyolojipipetSağlık ve tıpmesleki meslekbir kişilaboratuvar önlüğüTest Tübülaboratuvar ekipmanıkoruyucu iş giysisitıbbi araştırmabilimsel deneyCam malzemeBenzer İçerikler


Özel Boyut
(3648 x 5472, jpg)
Geniş Lisanslama
(3648 x 5472, jpg)
Eser Sahibi:
Tarih:
Warning: substr_count(): Empty substring in /home/lisansio/public_html/wp-content/themes/telifport_v3/inc-frontend/modal-urun-bilgileri.php on line 288